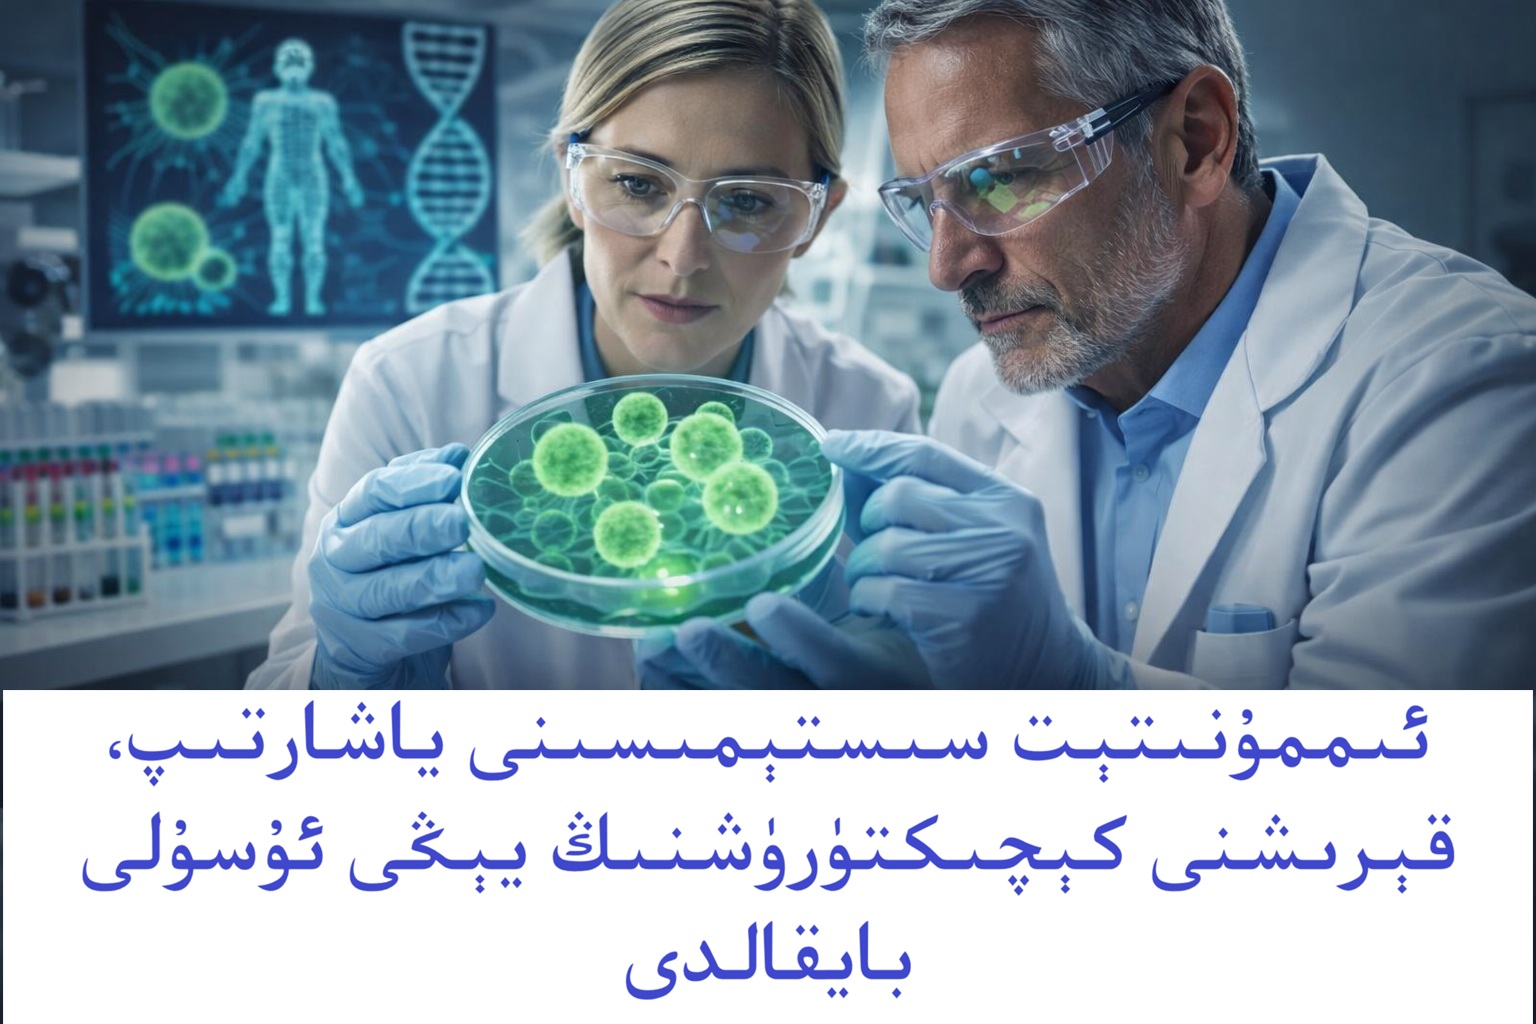
ئىممۇنىتېت سىستېمىسىنى ياشارتىپ، قېرىشنى كېچىكتۈرۈشنىڭ يېڭى ئۇسۇلى بايقالدى! ئىممۇنىتېت سىستېمىسىنى ياشارتىپ، قېرىشنى كېچىكتۈرۈشنىڭ يېڭى ئۇسۇلى بايقالدى!

ئىنسانىيەت قەدىمدىن تارتىپ «ئۆلمەسلىكنىڭ دورىسىنى تېپىش» ياكى ھېچ بولمىغاندا «قېرىماسلىقنىڭ سىرىنى ئېچىش» ئۈستىدە ئىزدىنىپ كەلگەن ئىدى. ئەنە شۇ ئارزۇ يېقىنقى زامان ئىلىم-پېنىدە رېئاللىققا ئايلىنىشقا يۈزلەنگەندەك تۇرىدۇ! كالىفورنىيەدىكى ئالىملار يېقىندا كىشىنى ھەيران قالدۇرىدىغان، ھەتتا «ئىنقىلاب خاراكتېرلىك» دەپ ئاتاشقا ئەرزىيدىغان بىر بايقاشنى ئېلان قىلدى. ئۇلار بەدىنىمىزدىكى ئاساسلىق قوغدىغۇچى – ئىممۇنىتېت سىستېمىسىنى پۈتۈنلەي ياشارتىپ، شۇ ئارقىلىق قېرىش جەريانىنى ئىزچىل ئاستىلىتىشنىڭ ئاچقۇچىنى تاپقانلىقىنى ئوتتۇرىغا قويدى. بۇ خەۋەر پۈتۈن دۇنيادىكى ساغلاملىق مۇتەخەسسىسلىرىنى ۋە كىشىلەرنىڭ قەلبىنى لەرزىگە سالدى!
تەن سىستېمىسىنىڭ جەڭچىسى: ئىممۇنىتېت سىستېمىسى نېمىشقا بۇنچە ھالقىلىق؟
تەسەۋۋۇر قىلىپ بېقىڭ، بەدىنىڭىزنى بىر قەلئەگە ئوخشاتساق، ئىممۇنىتېت سىستېمىسى دەل شۇ قەلئەنىڭ جەڭچىلىرى. بۇ جەڭچىلەر ۋىرۇسلار، باكتېرىيەلەر، راك ھۈجەيرىلىرى قاتارلىق ھەر خىل دۈشمەنلەرگە قارشى تىنمتاپماي جەڭ قىلىدۇ. لېكىن، ۋاقىتنىڭ ئۆتۈشى بىلەن، ياشنىڭ ئېشىشىغا ئەگىشىپ، بۇ جەڭچىلەرمۇ ئاجىزلايدۇ، كۈچتىن قالىدۇ، ھەرىكەتلىرى ئاستىلايدۇ. ئىلىم-پەن كەسپى ئاتالغۇسىدا بۇنى «ئىممۇنوسېنېسېنس (Immunosenescence)» يەنى «ئىممۇنىتېت سىستېمىسىنىڭ قېرىشى» دەپ ئاتايمىز. بۇ، بەدىنىمىزنىڭ
كېسەللىكلەرگە تاقابىل تۇرۇش ئىقتىدارىنىڭ تۆۋەنلىشى، ھاياتلىق كۈچىنىڭ خورىشى دېگەنلىك.
«قېرىغان ھۈجەيرىلەر» ئادەمنى قېرىتىشنىڭ سەۋەبچىسىمۇ؟
ئالىملارنىڭ بايقىشىچە، قېرىش جەريانىدىكى ھالقىلىق بىر سەۋەبچى «قېرىغان ھۈجەيرىلەر (Senescent Cells)» ئىكەن. بۇ ھۈجەيرىلەر، خۇددى پېنسىيە يېشىغا توشقان، ئەمما پېنسىيەگە چىقىشنى خالىمايدىغان، ئەكسىچە خىزمەت ئورنىدا قالايمىقانچىلىق چىقىرىدىغان خىزمەتچىلەرگە ئوخشاش. ئۇلار بەدەندە توپلىنىپ، ھۈجەيرە بۆلۈنۈشنى توختىتىدۇ، ئەمما ئۆلمەيدۇ. ئۇنىڭ ئورنىغا، ئەتراپىدىكى ساغلام ھۈجەيرىلەرگىمۇ زەھەرلىك ماددىلارنى چىقىرىپ، ياللۇغ پەيدا قىلىپ، ئىممۇنىتېت سىستېمىسىنىڭ ئىقتىدارىنى تۆۋەنلىتىپ، بەدەننىڭ قېرىش جەريانىنى تېزلىتىدۇ. بۇ «زومىگەر» ھۈجەيرىلەرنىڭ يىغىلىشى راك، يۈرەك كېسەللىكلىرى، دېمېنسىيە (ياشانغانلاردىكى دېۋەڭلىك) قاتارلىق نۇرغۇن ياشقا مۇناسىۋەتلىك كېسەللىكلەرنىڭ ئاساسلىق سەۋەبچىسى دەپ قارىلىدۇ.
پەقەتلام قېرىغان ھۈجەيرىلەرنى يوقىتىدىغان خىسلەتلىك مولېكۇلا
ئەمدى ئەڭ مۇھىم يېرى! ئالىملار مەلۇم بىر «بىئو-مولېكۇلا (Bio-molecule)»نىڭ بۇ ياشانغان ھۈجەيرىلەرنى نىشانلاپ يوقىتىش ئىقتىدارىغا ئىگە ئىكەنلىكىنى بايقىدى! خۇددى ئەقلىي ئىقتىدارلىق بىر باشقۇرۇلىدىغان بومبىغا ئوخشاش، بۇ مولېكۇلا پەقەت زىيانلىق، قېرىغان ھۈجەيرىلەرنىلا تېپىپ يوقىتىپ، ساغلام ھۈجەيرىلەرنى ساقلاپ قالىدىكەن. تۆۋەندە، بۇ مولېكۇلانىڭ بەدەندە قانداق رولى بار، شۇنى كۆرۈپ چىقايلى.
1. بايقاش: ئىممۇنىتېت قوشۇنلىرىنى ياشارتىش: بۇ مولېكۇلا ئىممۇنىتېت سىستېمىسىدىكى ئەڭ مۇھىم جەڭچىلەرنىڭ بىرى بولغان T ھۈجەيرىلىرى (T-cells) نىڭ ئىقتىدارىنى ئەسلىگە كەلتۈرۈپ، ئۇلارنى ياش ۋاقتىدىكىدەك جەسۇرلاشتۇرىدۇ.
2. بايقاش: قېرىشنى كەلتۈرۈپ چىقىرىدىغان ھۈجەيرىلەرنى پاكىزلاش: ياشانغان ھۈجەيرىلەرنى بەدەندىن چىقىرىپ تاشلاش ئارقىلىق، بەدەندىكى ياللۇغ پەيدا قىلىش جەريانىنى توختىتىپ، پۈتۈن بەدەننىڭ ياشىرىشقا باشلىشىغا شارائىت ھازىرلايدۇ.
3. بايقاش: كېسەللىكلەرگە قارشى تۇرۇش ئىقتىدارىنى ئاشۇرۇش: ئىممۇنىتېت سىستېمىسى كۈچەيگەنسېرى، راك، يۈرەك كېسەللىكلىرى، دىيابېت قاتارلىق نۇرغۇن كېسەللىكلەرگە تاقابىل تۇرۇش، ھەتتا ئۇلارنىڭ ئالدىنى ئېلىش ئىقتىدارىنىمۇ زور دەرىجىدە ئاشۇرىدۇ.
`
ئاخىرقى سۆز:
ئەمدى كەلگۈسىدە، ھەممىمىز «ئۆلمەسمىزمۇ»؟
ئەمدىلا باشلانغان بۇ تەتقىقات ئىنسانىيەتنىڭ كېسەللىكلەرگە تاقابىل تۇرۇش، ھاياتلىق سۈپىتىنى ئاشۇرۇش، ھەتتا ئۆمۈرنى ئۇزارتىش يولىدىكى ئەڭ چوڭ ئىلگىرىلەشلەرنىڭ بىرى بولۇشى مۇمكىن. ئالىملار بۇ مولېكۇلانى دورا شەكلىدە ياكى داۋالاش تېخنىكىلىرى ئارقىلىق ئىنسانلارغا قوللىنىشنى نىشان قىلماقتا. بۇ، پەقەت ياشاش ۋاقتىنى ئۇزارتىپلا قالماي، بەلكى ياشاش سۈپىتىنىمۇ زور دەرىجىدە ئاشۇرىدىغانلىقىدىن دېرەك بېرىدۇ. ياشنىڭ ئېشىشىغا ئەگىشىپ كۆرۈلىدىغان ئاغرىقلار، ئاجىزلىقلار بەلكىم تارىخقا ئايلىنىشى مۇمكىن.
`ئەمما شۇنى خۇلاسە شەكلىدە ئېيتىشقا مەجبۇرمىزكى، بۇ بايقاش كىشىنى ھەرقانچە ھاياجانغا سالغان بولسىمۇ، بىز يەنىلا ھازىرقى ساغلام تۇرمۇش ئادەتلىرىمىزنى ئۇنتۇماسلىقىمىز كېرەك. ئىلمىي ئوزۇقلىنىش، يېتەرلىك ئۇخلاش، دائىملىق چېنىقىش، ھەمدە روھىي بېسىمدىن يىراق تۇرۇش – بۇلار ئىممۇنىتېت سىستېمىمىزنى كۈچلۈك تۇتۇشنىڭ ئەڭ ئەقلىي، ئەڭ ئۈنۈملۈك ئۇسۇلى. ئىلىم-پەن بىزگە يېڭى ئۈمىد بېغىشلىسىمۇ، ساغلاملىق بىز ئۆزىمىزنىڭ قولىدا!
پايدىلانمىلار ۋە مەنبەلەر:
1. مەزمۇن ۋە ئىملا ئۇيغۇر ئېدىتتا تەھرىرلەندى. (غەيرەت كەنجى ئەپەندىمنىڭ تىل- يېزىقىمىزغا قىلغان خىزمىتىگە ئالاھىدە رەھمىتىمىزنى ئېيتىمىز)


